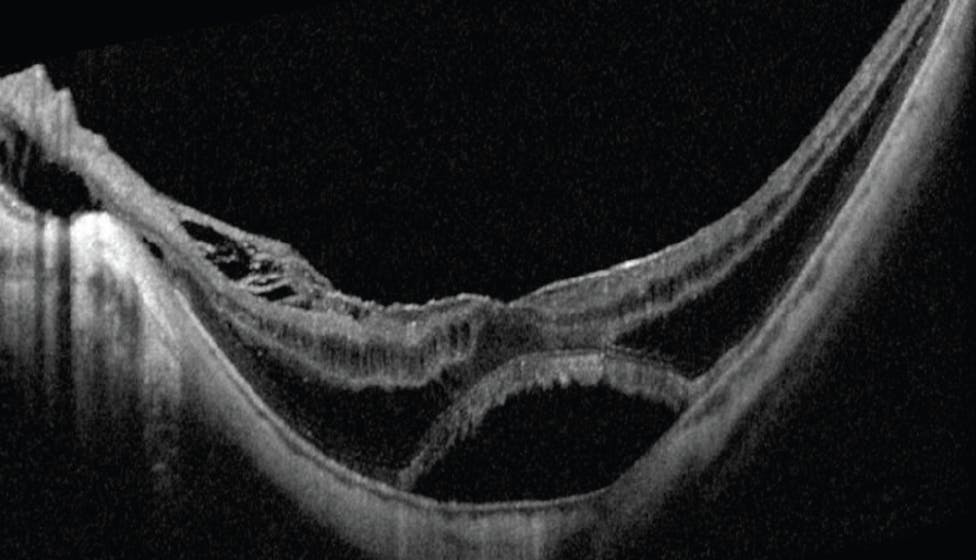

AT A GLANCE
- Scleral buckling has applications beyond primary rhegmatogenous retinal detachment, including for the treatment of myopic traction maculopathy.
- A review showed that resolution of foveoschisis, retinal reattachment, and macular hole closure were achieved more frequently with macular buckling than with vitrectomy.
- Intraoperative OCT may prove useful for confirming the accurate positioning of a macular buckle.
Scleral buckling is generally used to support peripheral retinal breaks to allow permanent closure, reduce vitreoretinal traction, and promote long-lasting chorioretinal adhesion. The buckling technique achieves these effects by bringing the retinal pigment epithelium (RPE) closer to the retina, which allows the subretinal fluid to be reabsorbed and leads to retinal reattachment.1
Scleral buckling techniques evolved from scleral resection, a procedure initially developed to reduce the size of the eyeball or strengthen the sclera and prevent stretching.2 In response to the complications associated with this approach, in 1949, Ernst Custodis designed an exoplant to produce a buckling effect for retinal detachment (RD) repair.3 Since then, many buckling techniques have been developed to treat RD.4
The volume of scleral buckling procedures has decreased as vitreoretinal surgeons, especially those who are young, increasingly perform pars plana vitrectomy (PPV) to repair primary rhegmatogenous RDs.5,6 However, scleral buckling has applications for many retinal conditions, including the treatment of myopic traction maculopathy (MTM). Macular buckling is a modified scleral buckling technique in which the buckle is placed in the posterior pole to provide scleral indentation in the area of the macula.
MYOPIC TRACTION MACULOPATHY
MTM refers to a broad clinical spectrum of conditions estimated to affect between 9% and 34% of eyes with pathologic myopia.7-9 MTM-inducing forces can lead to macular pathologies, such as macular schisis and macular detachment, inner lamellar macular hole, and full-thickness macular hole (Figure 1).10
Figure 1. OCT imaging demonstrates macular schisis and subretinal fluid in the left eye of a patient with MTM. A high-density OCT scan through the fovea should be used to identify a small macular hole.
There are several classifications for MTM. Shimada et al described retinoschisis in five stages and progression from macular retinoschisis to RD.11,12 Ruiz-Moreno et al proposed a classification and grading system for myopic maculopathy (ATN classification) that includes MTM.13 Parolini et al recently proposed a comprehensive OCT-based classification of MTM.10 These classifications are based on the progressive nature of MTM, with progressively decreasing vision.10,12,14
SURGICAL MANAGEMENT
The best surgical approach to MTM is a subject of debate. Though some researchers suggest that early-stage MTM can be observed because spontaneous improvement may occur,12,15 most ophthalmologists agree that surgery should be performed when patients’ visual acuity decreases and when they enter severe, sight-threatening stages of MTM, such as foveal detachment and macular hole RD (MHRD).16-18
Schepens described the macular buckling technique for the first time in 1957,19 and other researchers later reported the efficacy of this treatment in eyes with MHRD.20,21
PPV wasn’t introduced as a treatment for MHRD until the 1980s.22,23 Different types of intravitreal tamponades (eg, gas, silicone oil) and surgical techniques (internal limiting membrane [ILM] peeling and laser treatment) have been proposed for PPV for MHRD. However, anatomic results showed limited primary success rates for vitrectomy in highly myopic eyes.24 In addition, postoperative recurrence and postoperative macular hole recurrence have been reported in patients who undergo vitrectomy.25 These postoperative events may be related to the extended axial length and the persistent tangential traction on the retinal surface, related to posterior staphyloma, that remain after vitrectomy.
Modified vitrectomy approaches, such as foveal-sparing ILM peeling and inverted flaps, were recently proposed to improve anatomic outcomes, but the role of these approaches in MTM remains unclear. Furthermore, a review of 31 articles published over the course of 16 years comparing macular buckling with PPV for the treatment of MTM suggested that complete resolution of foveoschisis, retinal reattachment, and macular hole closure were achieved more frequently with macular buckling than with PPV.26 A recent randomized controlled study showed that macular buckling was superior to vitrectomy with ILM peeling plus gas tamponade for the surgical treatment of macular schisis and associated MHRD in high myopia.27 These studies have renewed researchers’ and clinicians’ interest in the macular buckling technique.
Macular Buckle Updates
The centrifugal MTM-inducing forces are both perpendicular and tangential to the retinal plane. The goal of macular buckling is to support the posterior staphyloma area by reducing various shearing forces and stretching and help to prevent the eventual failure of internal retinal structures, all of which are thought to induce MTM (Figure 2). The options for macular buckling include an ab externo approach with silicone bands or macular plombs. To date, the commercially available macular buckles are as follows:
- Ando Plombe (Ondeko)
- T-shaped scleral buckle (FCI, a Carl Zeiss Meditec Company)
- NPB macular buckle (AJL Ophthalmic)
- Adjustable MB (Micromed)
In the 2000s, macular buckling with a sponge and a solid silicone implant provided high reattachment rates for myopic MHRD,28,29 although it is a technically challenging procedure. Several updates to the buckle designs aimed to improve the surgical technique. For example, a T-shaped, semirigid, silicon rod-exoplant reinforced with titanium wires with an indenting head was proposed as an approach to MHRD in 2005.28 An L-shaped buckle with a titanium stent inserted into a silicon stent, allowing a macular indentation and anterior suture, was proposed to support a posterior staphyloma.30 Suprachoroidal buckling has also been proposed for MTM. In one technique, a catheter is used to deliver long-lasting hyaluronic acid into the suprachoroidal space in the area of the staphyloma in patients with MTM.31
VISUALIZATION OPTIONS
Despite the innovations described earlier, macular buckling remains a challenging surgery. One of the principal challenges is optimal positioning of the buckle. Some researchers reported using external posterior landmarks and adjustable macular buckles to facilitate better positioning of the indenting head, but this was associated with potential injury to the extraocular muscle.32,33 To avoid this problem and enhance visualization, Mateo et al proposed the insertion of an optical fiber coupled to an Ando Plombe, which allowed better visualization and positioning of the exoplant with an internal chandelier-assisted technique.34 A few recent case reports also showed the efficacy of internal chandelier-assisted techniques using a widefield contact lens system to repair myopic macular holes.35,36
Intraoperative OCT allows real-time visualization of the retinal layers and could provide important guidance for surgical decision making.37 Intraoperative OCT may prove useful for confirming the accurate positioning of a macular buckle. This technology may help surgeons overcome potential causes of surgical failure, such as excessive or insufficient posterior indentation, by allowing them to diagnose and address problems intraoperatively.
RETHINKING THE MACULAR BUCKLE
The macular buckling technique offers significant benefits for the treatment of MTM. Future advanced techniques and technologies may one day allow ophthalmologists to achieve even better surgical outcomes and wider clinical utility.
1. Rumpf J. Jules Gonin. Inventor of the surgical treatment for retinal detachment. Surv Ophthalmol. 1976;21(3):276-284.
2. Borley WE. The scleral resection (eyeball-shortening) operation. Trans Am Ophthalmol Soc. 1949;47:462-497.
3. Custodis E. Treatment of retinal detachment by circumscribed diathermal coagulation and by scleral depression in the area of tear caused by imbedding of a plastic implant. Article in German. Klin Monbl Augenheilkd Augenarztl Fortbild. 1956;129(4):476-495.
4. Wang A, Snead MP. Scleral buckling—a brief historical overview and current indications. Graefes Arch Clin Exp Ophthalmol. 2020;258(3):467-478.
5. Eibenberger K, Georgopoulos M, Rezar-Dreindl S, Schmidt-Erfurth U, Sacu S. Development of surgical management in primary rhegmatogenous retinal detachment treatment from 2009 to 2015. Curr Eye Res. 2018;43(4):517-525.
6. Nishitsuka K, Kawasaki R, Yamakiri K, et al. Preoperative factors to select vitrectomy or scleral buckling for retinal detachment in microincision vitrectomy era. Graefes Arch Clin Exp Ophthalmol. 2020;258(9):1871-1880.
7. Baba T, Ohno-Matsui K, Futagami S, et al. Prevalence and characteristics of foveal retinal detachment without macular hole in high myopia. Am J Ophthalmol. 2003;135(3):338-342.
8. Benhamou N, Massin P, Haouchine B, et al. Macular retinoschisis in highly myopic eyes. Am J Ophthalmol. 2002;133(6):794-800.
9. Panozzo G, Mercanti A. Optical coherence tomography findings in myopic traction maculopathy. Arch Ophthalmol. 2004;122(10):1455-1460.
10. Parolini B, Palmieri M, Finzi A, et al. The new myopic traction maculopathy staging system. Eur J Ophthalmol. 2021;31(3):1299-1312.
11. Shimada N, Ohno-Matsui K, Yoshida T, et al. Progression from macular retinoschisis to retinal detachment in highly myopic eyes is associated with outer lamellar hole formation. Br J Ophthalmol. 2008;92(6):762-764.
12. Shimada N, Tanaka Y, Tokoro T, Ohno-Matsui K. Natural course of myopic traction maculopathy and factors associated with progression or resolution. Am J Ophthalmol. 2013;156(5):948-57.e1.
13. Ruiz-Medrano J, Montero JA, Flores-Moreno I, Arias L, García-Layana A, Ruiz-Moreno JM. Myopic maculopathy: current status and proposal for a new classification and grading system (ATN). Prog Retin Eye Res. 2019;69:80-115.
14. Li S, Li T, Wang X, et al. Natural course of myopic traction maculopathy and factors influencing progression and visual acuity. BMC Ophthalmol. 2021;21(1):347.
15. Ratiglia R, Osnaghi S, Bindella A, Pirondini C. Posterior traction retinal detachment in highly myopic eyes: clinical features and surgical outcome as evaluated by optical coherence tomography. Retina. 2005;25(4):473-478.
16. Müller B, Joussen AM. Myopic traction maculopathy - vitreoretinal traction syndrome in high myopic eyes and posterior staphyloma. Article in German. Klin Monbl Augenheilkd. 2011;228(9):771-779.
17. Panozzo G, Mercanti A. Vitrectomy for myopic traction maculopathy. Arch Ophthalmol. 2007;125(6):767-772.
18. Kumagai K, Furukawa M, Ogino N, Larson E. Factors correlated with postoperative visual acuity after vitrectomy and internal limiting membrane peeling for myopic foveoschisis. Retina. 2010;30(6):874-880.
19. Schepens CL, Okamura ID, Brockhurst RJ. The scleral buckling procedures. I. Surgical techniques and management. AMA Arch Ophthalmol. 1957;58(6):797-811.
20. Rosengren B. The silver plomb method in macular holes. Trans Ophthalmol Soc UK. 1966;86:49-53.
21. Theodossiadis GP. A simplified technique for the surgical treatment of retinal detachments resulting from macula holes (author’s transl). Article in German. Klin Monbl Augenheilkd. 1973;162(6):719-728.
22. Gonvers M, Machemer R. A new approach to treating retinal detachment with macular hole. Am J Ophthalmol. 1982;94(4):468-472.
23. Oshima Y, Ikuno Y, Motokura M, Nakae K, Tano Y. Complete epiretinal membrane separation in highly myopic eyes with retinal detachment resulting from a macular hole. Am J Ophthalmol. 1998;126(5):669-676.
24. Ikuno Y, Sayanagi K, Oshima T, et al. Optical coherence tomographic findings of macular holes and retinal detachment after vitrectomy in highly myopic eyes. Am J Ophthalmol. 2003;136(3):477-481.
25. Kobayashi H, Kishi S. Vitreous surgery for highly myopic eyes with foveal detachment and retinoschisis. Ophthalmology. 2003;110(9):1702-1707.
26. Alkabes M, Mateo C. Macular buckle technique in myopic traction maculopathy: a 16-year review of the literature and a comparison with vitreous surgery. Graefes Arch Clin Exp Ophthalmol. 2018;256(5):863-877.
27. Liu B, Chen S, Li Y, et al. Comparison of macular buckling and vitrectomy for the treatment of macular schisis and associated macular detachment in high myopia: a randomized clinical trial. Acta Ophthalmol. 2020;98(3):e266-e72.
28. Tanaka T, Ando F, Usui M. Episcleral macular buckling by semirigid shaped-rod exoplant for recurrent retinal detachment with macular hole in highly myopic eyes. Retina. 2005;25(2):147-151.
29. Ripandelli G, Coppé AM, Fedeli R, Parisi V, D’Amico DJ, Stirpe M. Evaluation of primary surgical procedures for retinal detachment with macular hole in highly myopic eyes: a comparison [corrected] of vitrectomy versus posterior episcleral buckling surgery. Ophthalmology. 2001;108(12):2258-2264.
30. Parolini B, Frisina R, Pinackatt S, Mete M. A new L-shaped design of macular buckle to support a posterior staphyloma in high myopia. Retina. 2013;33(7):1466-1470.
31. El Rayes EN. Suprachoroidal buckling in managing myopic vitreoretinal interface disorders: 1-year data. Retina. 2014;34(1):129-135.
32. Siam AL, El-Mamoun TA, Ali MH. A restudy of the surgical anatomy of the posterior aspect of the globe: an essential topography for exact macular buckling. Retina. 2011;31(7):1405-1411.
33. Stirpe M, Ripandelli G, Rossi T, et al. A new adjustable macular buckle designed for highly myopic eyes. Retina. 2012;32(7):1424-1427.
34. Mateo C, Dutra Medeiros M, Alkabes M, et al. Illuminated Ando plombe for optimal positioning in highly myopic eyes with vitreoretinal diseases secondary to posterior staphyloma. JAMA Ophthalmol. 2013;131(10):1359-1362.
35. Forlini M, Szkaradek M, Rejdak R, et al. Modification of adjustable macular buckling with 29-G chandelier light for optimal positioning in highly myopic eyes with macular hole. Retin Cases Brief Rep. 2017;11(3):249-254.
36. Grewal PS, Seamone M, Greve M, et al. Internal chandelier-assisted macular buckling for myopic foveoschisis. Retina Cases Brief Rep. 2022;16(4):532-535.
37. Ehlers JP, Kaiser PK, Srivastava SK. Intraoperative optical coherence tomography using the Rescan 700: preliminary results from the DISCOVER study. Br J Ophthalmol. 2014;98(10):1329-1332.




















